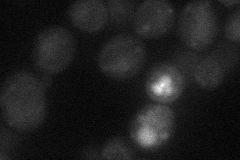
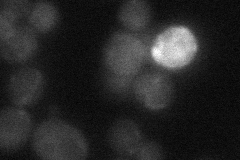

View description
Protein with both structural and functional similarity to Mid2p, which is a plasma membrane sensor required for cell integrity signaling during pheromone-induced morphogenesis; suppresses rgd1 null mutations
Localization:
Intensity:
Fold change:
Significance:
-
C’ GFP library in SD

cytosol19.89 -
N' NOP1pr-GFP in SD
below threshold18.7525 -
N' TEF2pr-mCherry in SD

vacuole7.51514 -
N' NATIVEpr-GFP in SD
below threshold17.1792 -
N' TEF2pr-VC and Cyto-VN in SD

#N/A0 -
C’ GFP library in SD+DTT

cytosol21.651.08No -
C’ GFP library in SD+H2O2

cytosol20.871.04No -
C’ GFP library in Starvation Media

cytosol24.121.21No -
C’ GFP library on the background of Pup2-DaMP

cytosol -
C’ GFP library on the background of CCT mutant

cytosol20.10111.01035No
